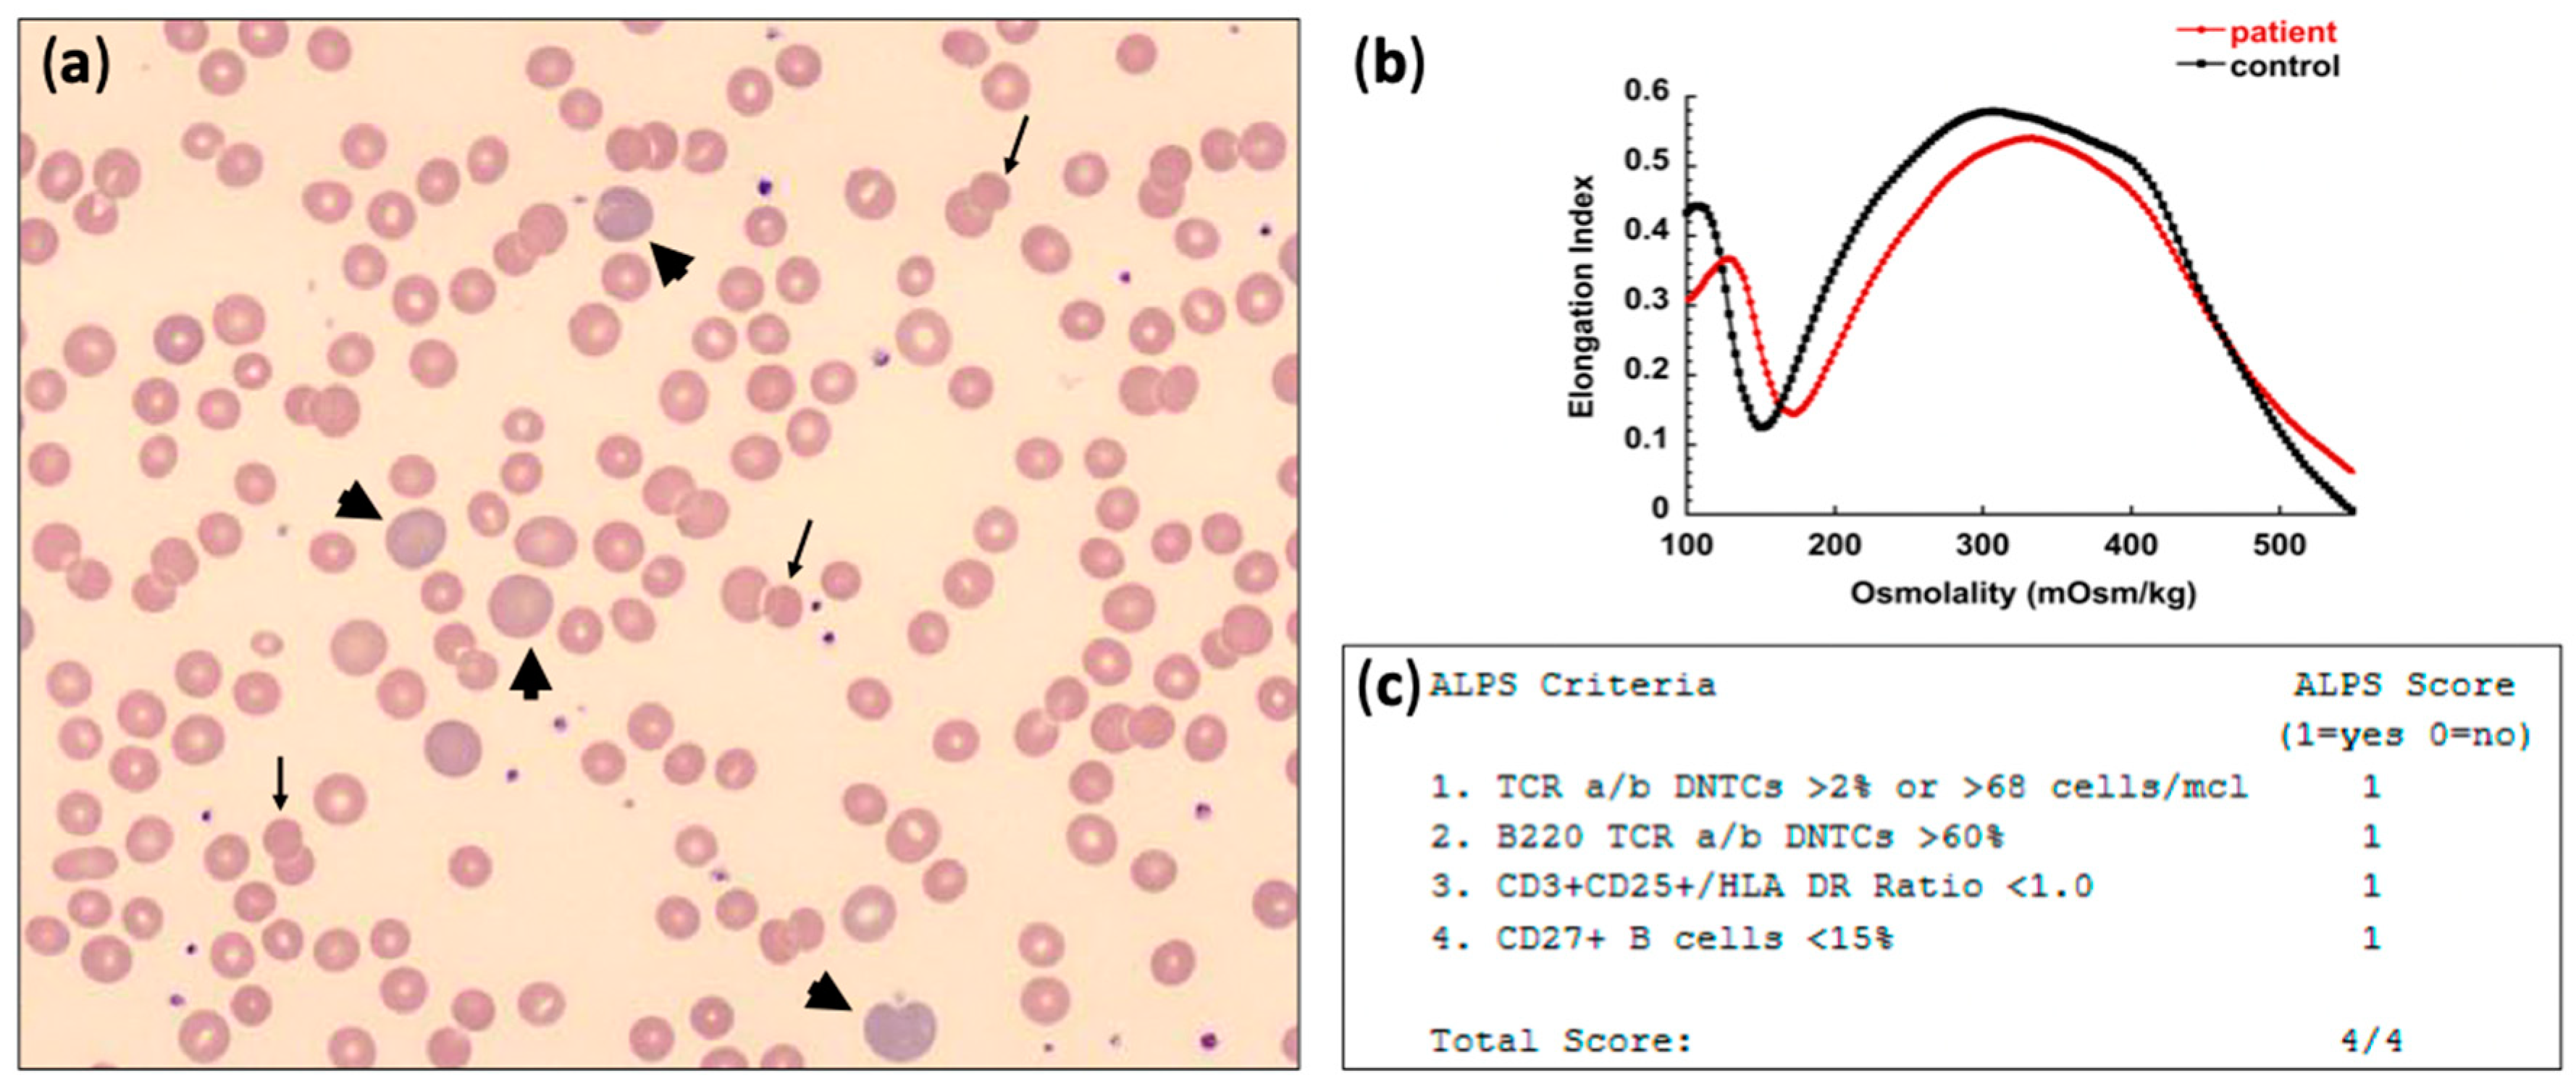
Jcm 10 00216 g001

Autoimmune Hemolytic Anemia in the Pediatric Setting
Abstract
1. Introduction
2. Warm Antibody AIHA (w-AIHA)
2.1. Pathophysiology and Underlying Etiology
2.2. Clinical and Laboratory Findings
2.3. Treatment Considerations
3. Cold Agglutinin Disease (CAD) due to IgM Antibody
3.1. Pathophysiology and Underlying Etiology
3.2. Clinical and Laboratory Findings
3.3. Treatment Considerations
4. Paroxysmal Cold Hemoglobinuria (PCH)
4.1. Pathophysiology and Underlying Etiology
4.2. Clinical and Laboratory Findings
4.3. Treatment Considerations
Author Contributions
Funding
Institutional Review Board Statement
Informed Consent Statement
Data Availability Statement
Conflicts of Interest
References
- Hill, Q.A.; Hill, A.; Berentsen, S. Defining autoimmune hemolytic anemia: A systematic review of the terminology used for diagnosis and treatment. Blood Adv. 2019, 3, 1897–1906. [Google Scholar] [CrossRef] [PubMed]
- Michel, M. Classification and therapeutic approaches in autoimmune hemolytic anemia: An update. Expert Rev. Hematol. 2011, 4, 607–618. [Google Scholar] [CrossRef] [PubMed]
- Aladjidi, N.; Jutand, M.A.; Beaubois, C.; Fernandes, H.; Jeanpetit, J.; Coureau, G.; Gilleron, V.; Kostrzewa, A.; Lauroua, P.; Jeanne, M.; et al. Reliable assessment of the incidence of childhood autoimmune hemolytic anemia. Pediatr. Blood Cancer 2017, 64, e26683. [Google Scholar] [CrossRef] [PubMed]
- Aladjidi, N.; Leverger, G.; Leblanc, T.; Picat, M.Q.; Michel, G.; Bertrand, Y.; Bader-Meunier, B.; Robert, A.; Nelken, B.; Gandemer, V.; et al. New insights into childhood autoimmune hemolytic anemia: A French national observational study of 265 children. Haematologica 2011, 96, 655–663. [Google Scholar] [CrossRef]
- Vaglio, S.; Arista, M.C.; Perrone, M.P.; Tomei, G.; Testi, A.M.; Coluzzi, S.; Girelli, G. Autoimmune hemolytic anemia in childhood: Serologic features in 100 cases. Transfusion 2007, 47, 50–54. [Google Scholar] [CrossRef]
- Sankaran, J.; Rodriguez, V.; Jacob, E.K.; Kreuter, J.D.; Go, R.S. Autoimmune Hemolytic Anemia in Children: Mayo Clinic Experience. J. Pediatr. Hematol. Oncol. 2016, 38, e120–e124. [Google Scholar] [CrossRef]
- Gehrs, B.C.; Friedberg, R.C. Autoimmune hemolytic anemia. Am. J. Hematol. 2002, 69, 258–271. [Google Scholar] [CrossRef]
- Kalfa, T.A. Warm antibody autoimmune hemolytic anemia. Hematol. Am. Soc. Hematol. Educ. Program 2016, 2016, 690–697. [Google Scholar] [CrossRef]
- Naithani, R.; Agrawal, N.; Mahapatra, M.; Kumar, R.; Pati, H.P.; Choudhry, V.P. Autoimmune hemolytic anemia in children. Pediatr. Hematol. Oncol. 2007, 24, 309–315. [Google Scholar] [CrossRef]
- Segel, G.B.; Lichtman, M.A. Direct antiglobulin (“Coombs”) test-negative autoimmune hemolytic anemia: A review. Blood Cells Mol. Dis. 2014, 52, 152–160. [Google Scholar] [CrossRef]
- Risinger, M.; Kalfa, T.A. Red cell membrane disorders: Structure meets function. Blood 2020, 136, 1250–1261. [Google Scholar] [CrossRef] [PubMed]
- Barcellini, W.; Fattizzo, B. The Changing Landscape of Autoimmune Hemolytic Anemia. Front. Immunol. 2020, 11, 946. [Google Scholar] [CrossRef] [PubMed]
- Branstetter, C.N.; Hankins, J.S.; Moreau, D.; Nottage, K.A. Severe Autoimmune Hemolytic Anemia in an Infant Caused by Warm-reactive IGM and IGA Autoantibodies: A Case Report and Review of the Literature. J. Pediatr. Hematol. Oncol. 2015, 37, 468–471. [Google Scholar] [CrossRef] [PubMed]
- Berentsen, S.; Hill, A.; Hill, Q.A.; Tvedt, T.H.A.; Michel, M. Novel insights into the treatment of complement-mediated hemolytic anemias. Ther. Adv. Hematol. 2019, 10. [Google Scholar] [CrossRef] [PubMed]
- Kanellopoulou, T. Autoimmune hemolytic anemia in solid organ transplantation-The role of immunosuppression. Clin. Transplant. 2017, 31, e13031. [Google Scholar] [CrossRef]
- Johnson, S.T.; Fueger, J.T.; Gottschall, J.L. One center’s experience: The serology and drugs associated with drug-induced immune hemolytic anemia--a new paradigm. Transfusion 2007, 47, 697–702. [Google Scholar] [CrossRef]
- Rivalta, B.; Zama, D.; Pancaldi, G.; Facchini, E.; Cantarini, M.E.; Miniaci, A.; Prete, A.; Pession, A. Evans Syndrome in Childhood: Long Term Follow-Up and the Evolution in Primary Immunodeficiency or Rheumatological Disease. Front. Pediatr. 2019, 7, 304. [Google Scholar] [CrossRef]
- Jaime-Perez, J.C.; Aguilar-Calderon, P.E.; Salazar-Cavazos, L.; Gomez-Almaguer, D. Evans syndrome: Clinical perspectives, biological insights and treatment modalities. J. Blood Med. 2018, 9, 171–184. [Google Scholar] [CrossRef]
- Hadjadj, J.; Aladjidi, N.; Fernandes, H.; Leverger, G.; Magerus-Chatinet, A.; Mazerolles, F.; Stolzenberg, M.C.; Jacques, S.; Picard, C.; Rosain, J.; et al. Pediatric Evans syndrome is associated with a high frequency of potentially damaging variants in immune genes. Blood 2019, 134, 9–21. [Google Scholar] [CrossRef]
- Velo-Garcia, A.; Castro, S.G.; Isenberg, D.A. The diagnosis and management of the haematologic manifestations of lupus. J. Autoimmun. 2016, 74, 139–160. [Google Scholar] [CrossRef]
- Maggiore, G.; Sciveres, M.; Fabre, M.; Gori, L.; Pacifico, L.; Resti, M.; Choulot, J.J.; Jacquemin, E.; Bernard, O. Giant cell hepatitis with autoimmune hemolytic anemia in early childhood: Long-term outcome in 16 children. J. Pediatr. 2011, 159, 127–132. [Google Scholar] [CrossRef] [PubMed]
- Raj, S.; Stephen, T.; Debski, R.F. Giant cell hepatitis with autoimmune hemolytic anemia: A case report and review of pediatric literature. Clin. Pediatr. 2011, 50, 357–359. [Google Scholar] [CrossRef] [PubMed]
- Brichard, B.; Sokal, E.; Gosseye, S.; Buts, J.P.; Gadisseux, J.F.; Cornu, G. Coombs-positive giant cell hepatitis of infancy: Effect of steroids and azathioprine therapy. Eur. J. Pediatr. 1991, 150, 314–317. [Google Scholar] [CrossRef] [PubMed]
- Bernard, O.; Hadchouel, M.; Scotto, J.; Odievre, M.; Alagille, D. Severe giant cell hepatitis with autoimmune hemolytic anemia in early childhood. J. Pediatr. 1981, 99, 704–711. [Google Scholar] [CrossRef]
- Bouguila, J.; Mabrouk, S.; Tilouche, S.; Bakir, D.; Trabelsi, A.; Hmila, A.; Boughammoura, L. Giant cell hepatitis with autoimmune hemolytic anemia in a nine month old infant. World J. Hepatol. 2013, 5, 226–229. [Google Scholar] [CrossRef]
- Bakula, A.; Socha, P.; Klaudel-Dreszler, M.; Karolczyk, G.; Wozniak, M.; Rutynowska-Pronicka, O.; Matysiak, M. Giant cell hepatitis with autoimmune hemolytic anemia in children: Proposal for therapeutic approach. J. Pediatr. Gastroenterol. Nutr. 2014, 58, 669–673. [Google Scholar] [CrossRef]
- Paganelli, M.; Patey, N.; Bass, L.M.; Alvarez, F. Anti-CD20 treatment of giant cell hepatitis with autoimmune hemolytic anemia. Pediatrics 2014, 134, e1206–e1210. [Google Scholar] [CrossRef]
- Whitington, P.F.; Vos, M.B.; Bass, L.M.; Melin-Aldana, H.; Romero, R.; Roy, C.C.; Alvarez, F. Humoral immune mechanism of liver injury in giant cell hepatitis with autoimmune hemolytic anemia. J. Pediatr. Gastroenterol. Nutr. 2014, 58, 74–80. [Google Scholar] [CrossRef]
- Miloh, T.; Manwani, D.; Morotti, R.; Sukru, E.; Shneider, B.; Kerkar, N. Giant cell hepatitis and autoimmune hemolytic anemia successfully treated with rituximab. J. Pediatr. Gastroenterol. Nutr. 2007, 44, 634–636. [Google Scholar] [CrossRef]
- Teachey, D.T.; Lambert, M.P. Diagnosis and management of autoimmune cytopenias in childhood. Pediatr. Clin. N. Am. 2013, 60, 1489–1511. [Google Scholar] [CrossRef]
- Weli, M.; Ben Hlima, A.; Belhadj, R.; Maalej, B.; Elleuch, A.; Mekki, N.; Gargouri, L.; Kamoun, T.; Barbouche, M.R.; Mahfoudh, A. Diagnosis and management of autoimmune hemolytic anemia in children. Transfus. Clin. Biol. 2020, 27, 61–64. [Google Scholar] [CrossRef] [PubMed]
- Hill, Q.A.; Stamps, R.; Massey, E.; Grainger, J.D.; Provan, D.; Hill, A.; British Society for Haematology. The diagnosis and management of primary autoimmune haemolytic anaemia. Br. J. Haematol. 2017, 176, 395–411. [Google Scholar] [CrossRef] [PubMed]
- Ozsoylu, F. Megadose methylprednisolone for the treatment of patients with Evans syndrome. Pediatr. Hematol. Oncol. 2004, 21, 739–740. [Google Scholar] [CrossRef] [PubMed]
- Zanella, A.; Barcellini, W. Treatment of autoimmune hemolytic anemias. Haematologica 2014, 99, 1547–1554. [Google Scholar] [CrossRef]
- Petz, L.D. A physician’s guide to transfusion in autoimmune haemolytic anaemia. Br. J. Haematol. 2004, 124, 712–716. [Google Scholar] [CrossRef]
- Flores, G.; Cunningham-Rundles, C.; Newland, A.C.; Bussel, J.B. Efficacy of intravenous immunoglobulin in the treatment of autoimmune hemolytic anemia: Results in 73 patients. Am. J. Hematol. 1993, 44, 237–242. [Google Scholar] [CrossRef]
- Zecca, M.; Nobili, B.; Ramenghi, U.; Perrotta, S.; Amendola, G.; Rosito, P.; Jankovic, M.; Pierani, P.; De Stefano, P.; Bonora, M.R.; et al. Rituximab for the treatment of refractory autoimmune hemolytic anemia in children. Blood 2003, 101, 3857–3861. [Google Scholar] [CrossRef]
- Miano, M.; Scalzone, M.; Perri, K.; Palmisani, E.; Caviglia, I.; Micalizzi, C.; Svahn, J.; Calvillo, M.; Banov, L.; Terranova, P.; et al. Mycophenolate mofetil and Sirolimus as second or further line treatment in children with chronic refractory Primitive or Secondary Autoimmune Cytopenias: A single centre experience. Br. J. Haematol. 2015, 171, 247–253. [Google Scholar] [CrossRef]
- Bride, K.L.; Vincent, T.; Smith-Whitley, K.; Lambert, M.P.; Bleesing, J.J.; Seif, A.E.; Manno, C.S.; Casper, J.; Grupp, S.A.; Teachey, D.T. Sirolimus is effective in relapsed/refractory autoimmune cytopenias: Results of a prospective multi-institutional trial. Blood 2016, 127, 17–28. [Google Scholar] [CrossRef]
- Crary, S.E.; Buchanan, G.R. Vascular complications after splenectomy for hematologic disorders. Blood 2009, 114, 2861–2868. [Google Scholar] [CrossRef]
- Rao, V.K. Approaches to Managing Autoimmune Cytopenias in Novel Immunological Disorders with Genetic Underpinnings Like Autoimmune Lymphoproliferative Syndrome. Front. Pediatr. 2015, 3, 65. [Google Scholar] [CrossRef] [PubMed]
- Price, S.; Shaw, P.A.; Seitz, A.; Joshi, G.; Davis, J.; Niemela, J.E.; Perkins, K.; Hornung, R.L.; Folio, L.; Rosenberg, P.S.; et al. Natural history of autoimmune lymphoproliferative syndrome associated with FAS gene mutations. Blood 2014, 123, 1989–1999. [Google Scholar] [CrossRef] [PubMed]
- Bride, K.; Teachey, D. Autoimmune lymphoproliferative syndrome: More than a FAScinating disease. F1000 Res. 2017, 6, 1928. [Google Scholar] [CrossRef] [PubMed]
- Teachey, D.T.; Seif, A.E.; Grupp, S.A. Advances in the management and understanding of autoimmune lymphoproliferative syndrome (ALPS). Br. J. Haematol. 2010, 148, 205–216. [Google Scholar] [CrossRef]
- Schubert, D.; Bode, C.; Kenefeck, R.; Hou, T.Z.; Wing, J.B.; Kennedy, A.; Bulashevska, A.; Petersen, B.S.; Schaffer, A.A.; Gruning, B.A.; et al. Autosomal dominant immune dysregulation syndrome in humans with CTLA4 mutations. Nat. Med. 2014, 20, 1410–1416. [Google Scholar] [CrossRef]
- Lo, B.; Zhang, K.; Lu, W.; Zheng, L.; Zhang, Q.; Kanellopoulou, C.; Zhang, Y.; Liu, Z.; Fritz, J.M.; Marsh, R.; et al. AUTOIMMUNE DISEASE. Patients with LRBA deficiency show CTLA4 loss and immune dysregulation responsive to abatacept therapy. Science 2015, 349, 436–440. [Google Scholar] [CrossRef]
- Dall’Era, M.; Davis, J. CTLA4Ig: A novel inhibitor of costimulation. Lupus 2004, 13, 372–376. [Google Scholar] [CrossRef]
- Schwab, C.; Gabrysch, A.; Olbrich, P.; Patino, V.; Warnatz, K.; Wolff, D.; Hoshino, A.; Kobayashi, M.; Imai, K.; Takagi, M.; et al. Phenotype, penetrance, and treatment of 133 cytotoxic T-lymphocyte antigen 4-insufficient subjects. J. Allergy Clin. Immunol. 2018, 142, 1932–1946. [Google Scholar] [CrossRef]
- Hess, J.; Su, L.; Nizzi, F.; Beebe, K.; Magee, K.; Salzberg, D.; Stahlecker, J.; Miller, H.K.; Adams, R.H.; Ngwube, A. Successful treatment of severe refractory autoimmune hemolytic anemia after hematopoietic stem cell transplant with abatacept. Transfusion 2018, 58, 2122–2127. [Google Scholar] [CrossRef]
- Berentsen, S. How I manage patients with cold agglutinin disease. Br. J. Haematol. 2018, 181, 320–330. [Google Scholar] [CrossRef]
- Habibi, B.; Homberg, J.C.; Schaison, G.; Salmon, C. Autoimmune hemolytic anemia in children. A review of 80 cases. Am. J. Med. 1974, 56, 61–69. [Google Scholar] [CrossRef]
- Terada, K.; Tanaka, H.; Mori, R.; Kataoka, N.; Uchikawa, M. Hemolytic anemia associated with cold agglutinin during chickenpox and a review of the literature. J. Pediatr. Hematol. Oncol. 1998, 20, 149–151. [Google Scholar] [CrossRef] [PubMed]
- Singh, A.; Mandal, A.; Patel, A.; Mishra, S. Autoimmune Haemolytic Anaemia-A Spectrum of Presentation in Children. J. Clin. Diagn. Res. 2017, 11, SR01–SR02. [Google Scholar] [CrossRef] [PubMed]
- Lee, S.C.; Youn, Y.S.; Rhim, J.W.; Kang, J.H.; Lee, K.Y. Early Serologic Diagnosis of Mycoplasma pneumoniae Pneumonia: An Observational Study on Changes in Titers of Specific-IgM Antibodies and Cold Agglutinins. Medicine 2016, 95, e3605. [Google Scholar] [CrossRef]
- Petz, L.D. Cold antibody autoimmune hemolytic anemias. Blood Rev. 2008, 22, 1–15. [Google Scholar] [CrossRef]
- Hill, A.; Hill, Q.A. Autoimmune hemolytic anemia. Hematol. Am. Soc. Hematol. Educ. Program 2018, 2018, 382–389. [Google Scholar] [CrossRef]
- Gertz, M.A. Cold hemolytic syndrome. Hematol. Am. Soc. Hematol. Educ. Program 2006, 19–23. [Google Scholar] [CrossRef][Green Version]
- Daxbock, F.; Zedtwitz-Liebenstein, K.; Burgmann, H.; Graninger, W. Severe hemolytic anemia and excessive leukocytosis masking mycoplasma pneumonia. Ann. Hematol. 2001, 80, 180–182. [Google Scholar] [CrossRef]
- Bird, G.W.; Wingham, J.; Martin, A.J.; Richardson, S.G.; Cole, A.P.; Payne, R.W.; Savage, B.F. Idiopathic non-syphilitic paroxysmal cold haemoglobinuria in children. J. Clin. Pathol. 1976, 29, 215–218. [Google Scholar] [CrossRef]
- Wishart, M.M.; Davey, M.G. Infectious mononucleosis complicated by acute haemolytic anaemia with a positive Donath-Landsteiner reaction. J. Clin. Pathol. 1973, 26, 332–334. [Google Scholar] [CrossRef]
- Gottsche, B.; Salama, A.; Mueller-Eckhardt, C. Donath-Landsteiner autoimmune hemolytic anemia in children. A study of 22 cases. Vox Sang. 1990, 58, 281–286. [Google Scholar] [CrossRef] [PubMed]
- Heddle, N.M. Acute paroxysmal cold hemoglobinuria. Transfus. Med. Rev. 1989, 3, 219–229. [Google Scholar] [CrossRef]
- Mukhopadhyay, S.; Keating, L.; Souid, A.K. Erythrophagocytosis in paroxysmal cold hemoglobinuria. Am. J. Hematol. 2003, 74, 196–197. [Google Scholar] [CrossRef] [PubMed]
- Shanbhag, S.; Spivak, J. Paroxysmal cold hemoglobinuria. Hematol. Oncol. Clin. N. Am. 2015, 29, 473–478. [Google Scholar] [CrossRef]
| Type | Antibody Class | T of Maximal Reactivity | DAT Positivity |
|---|---|---|---|
| Warm antibody AIHA (w-AIHA) | IgG | 37 °C | IgG ± C3 |
| Cold agglutinin syndrome (CAS) | IgM | 4 °C | C3 only |
| Mixed AIHA | cold IgM and warm IgG | 4 °C and 37 °C | IgG and C3 |
| Paroxysmal cold hemoglobinuria (PCH) | IgG | 4 °C | ±C3 |
| HEREDITARY HEMOLYTIC ANEMIAS |
Membrane defects
|
Enzymopathies
|
Hemoglobin disorders
|
| Congenital dyserythropoietic anemias |
| ACQUIRED HEMOLYTIC ANEMIAS |
Autoimmune hemolytic anemia (AIHA)
|
Alloimmune hemolytic anemia
|
Traumatic Hemolytic Anemia
|
| Hypersplenism |
Hemolytic Anemia due to toxic effects on the membrane
|
| Paroxysmal nocturnal hemoglobinuria |
| Initial Laboratory Evaluation of AIHA |
| Complete blood count (CBC) with differential Reticulocyte count (absolute reticulocyte count (ARC) is preferable) Peripheral blood smear review |
| Direct antiglobulin test (DAT) Type and Screen [Screen is performed by the Indirect Antiglobulin Test (IAT)] Follow-up evaluations include:
|
| Serum markers of hemolysis (i.e., total and unconjugated bilirubin, lactate dehydrogenase, haptoglobin) Liver and kidney function tests |
| Urine hemoglobin and hemosiderin evaluation may be used to differentiate intravascular (positive result) versus extravascular hemolysis |
| Bone marrow aspirate and biopsy in atypical cases where there is a concern for underlying malignancy, e.g., concurrent thrombocytopenia and/or neutropenia, unusual or prolonged reticulocytopenia, lymphadenopathy or organomegaly without evidence of concurrent EBV infection. |
| In cases of w-AIHA, consider possibility for underlying causes |
| Screen for primary immune disorder (PID) on a sample obtained before treatment initiation IgG, IgM, IgA quantification Lymphocyte subpopulations by flow cytometry Autoimmune lymphoproliferative syndrome (ALPS) screening panel by flow cytometry Follow-up testing as needed with next-generation sequencing on ALPS or PID gene panels |
| Screen for rheumatologic diseases (frequently indicated in teenager females) Antinuclear antibodies Anti-double-stranded DNA antibodies |
| HIV testing |
Publisher’s Note: MDPI stays neutral with regard to jurisdictional claims in published maps and institutional affiliations. |
© 2021 by the authors. Licensee MDPI, Basel, Switzerland. This article is an open access article distributed under the terms and conditions of the Creative Commons Attribution (CC BY) license (http://creativecommons.org/licenses/by/4.0/).
Share and Cite
Voulgaridou, A.; Kalfa, T.A. Autoimmune Hemolytic Anemia in the Pediatric Setting. J. Clin. Med. 2021, 10, 216. https://doi.org/10.3390/jcm10020216
Voulgaridou A, Kalfa TA. Autoimmune Hemolytic Anemia in the Pediatric Setting. Journal of Clinical Medicine. 2021; 10(2):216. https://doi.org/10.3390/jcm10020216
Chicago/Turabian StyleVoulgaridou, Aikaterini, and Theodosia A. Kalfa. 2021. "Autoimmune Hemolytic Anemia in the Pediatric Setting" Journal of Clinical Medicine 10, no. 2: 216. https://doi.org/10.3390/jcm10020216
APA StyleVoulgaridou, A., & Kalfa, T. A. (2021). Autoimmune Hemolytic Anemia in the Pediatric Setting. Journal of Clinical Medicine, 10(2), 216. https://doi.org/10.3390/jcm10020216

